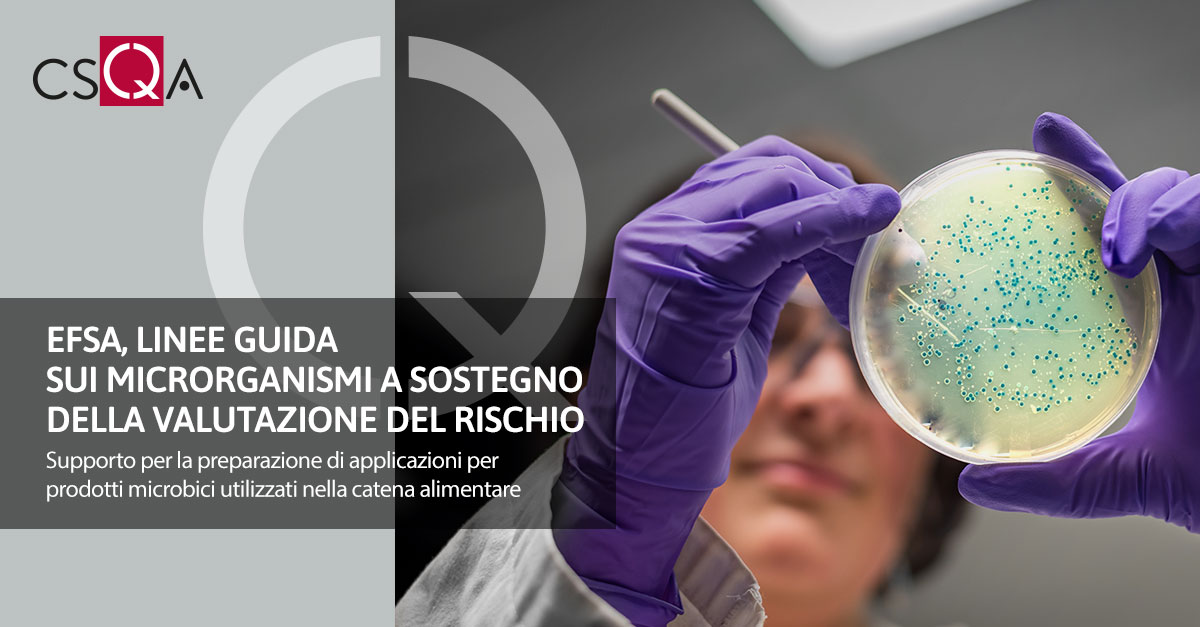
EFSA, Linee guida sulla caratterizzazione dei microrganismi a sostegno della valutazione del rischio

EFSA ha pubblicato una nuova guida per armonizzare la caratterizzazione dei microrganismi in aree quali gli additivi per alimenti e mangimi, gli enzimi alimentari, i nuovi alimenti e altro ancora.
EFSA ha pubblicato una nuova guida per armonizzare la caratterizzazione dei microrganismi in aree quali gli additivi per alimenti e mangimi, gli enzimi alimentari, i nuovi alimenti e altro ancora.Le linee guida Guidance on the characterisation of microorganisms in supportof the risk assessment of products used in the food chain supportano la preparazione di applicazioni per prodotti microbici utilizzati nella catena alimentare, come batteri, funghi, microalghe, virus e prodotti correlati.
Fornisce pertanto orientamenti per la preparazione di richieste di autorizzazione per prodotti regolamentati da utilizzare nella catena alimentare, contenenti, realizzati o prodotti utilizzando microrganismi, geneticamente modificati o meno, che sono soggetti a valutazione del rischio nell'ambito del mandato dell'EFSA prima della loro immissione sul mercato dell'UE.
La presente guida si concentra sui requisiti scientifici per caratterizzare i microrganismi e, in una certa misura, i loro prodotti.
Fornisce la base per l'identificazione dei pericoli a sostegno della valutazione del rischio da microrganismi e stabilisce i requisiti in materia di dati per condurre la valutazione del rischio.
Vantaggi
- Un grande passo avanti verso l'allineamento tra le aree di lavoro
- Un processo più chiaro per i richiedenti
- Maggiore coerenza tra le valutazioni